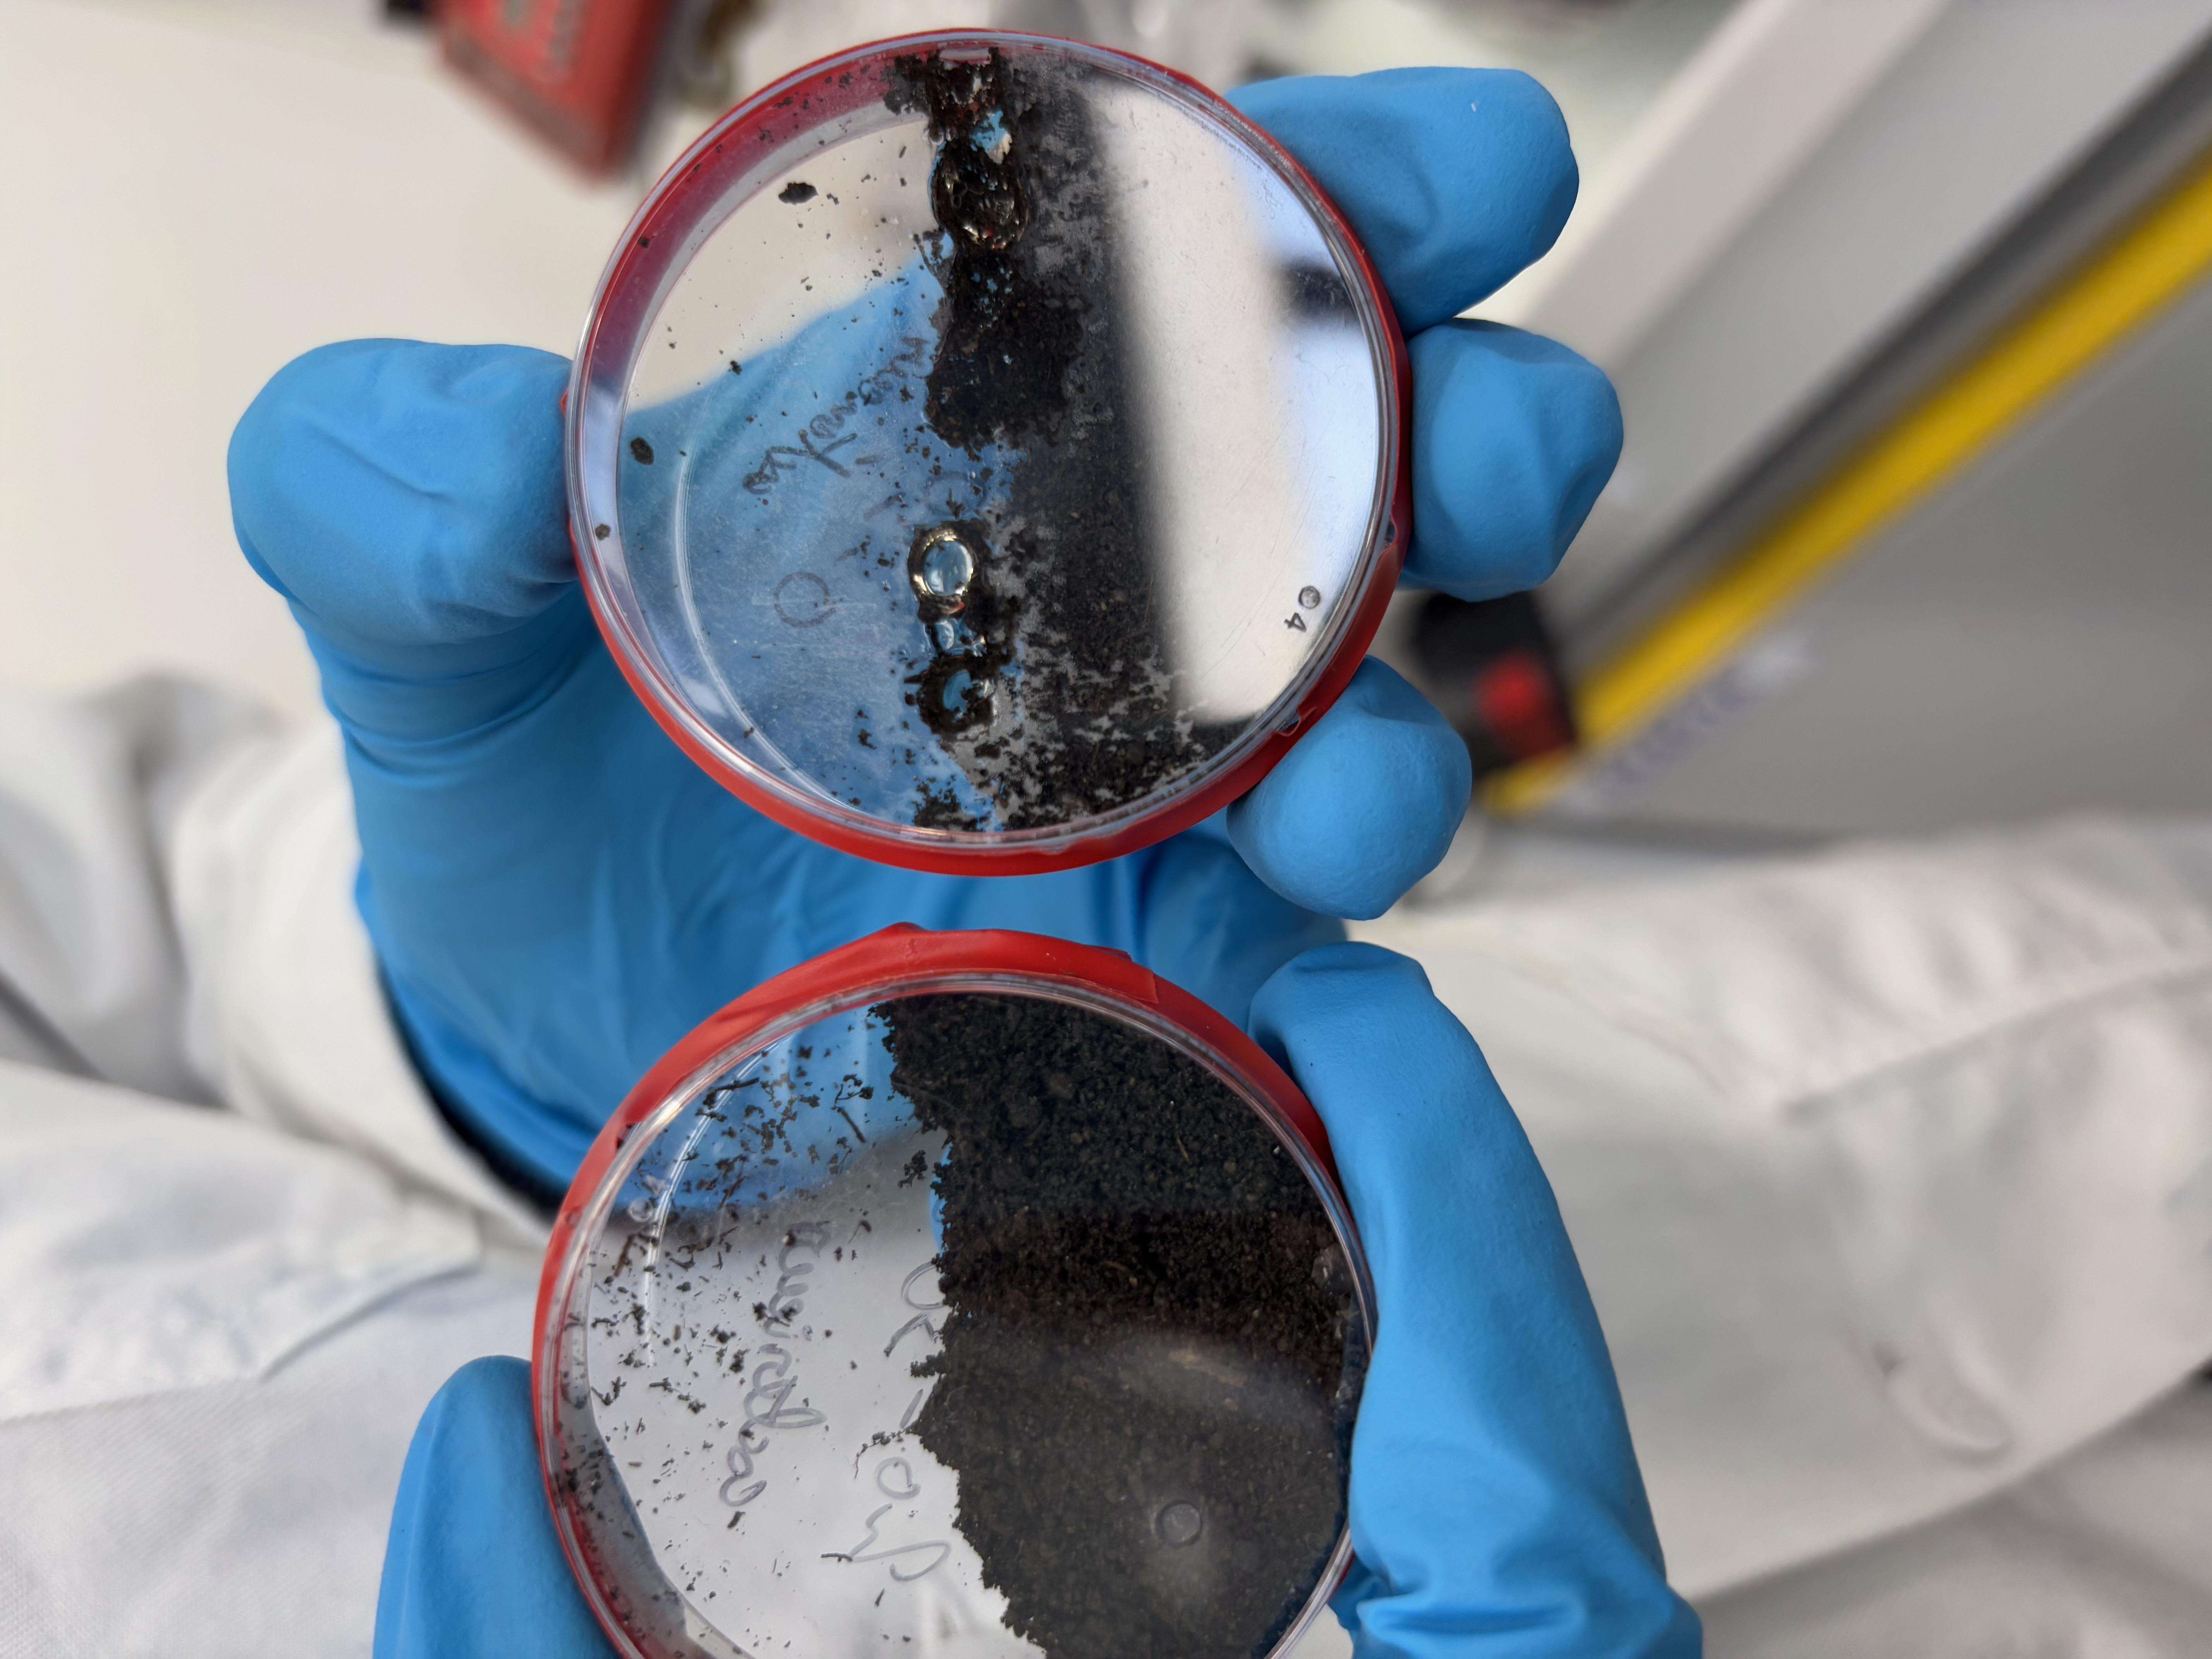

Billes d’alginate hydro-régulatrices : une innovation durable
Dans le cadre d’un projet MTX (Matériaux – Chimie), des étudiants ont développé une solution innovante visant à améliorer la gestion de l’eau au sein de la serre géodésique de Saint-Cyr-l’École. Cette innovation repose sur l’utilisation de billes d’alginate hydro-régulatrices, conçues pour optimiser l’arrosage et limiter le gaspillage de la ressource en eau.
Une innovation issue de la chimie des matériaux
Les billes sont fabriquées à partir d’algues naturelles réticulées. Leur structure chimique spécifique leur permet d’absorber l’eau lors de l’arrosage, de la stocker temporairement, puis de la restituer progressivement au sol. Ce mécanisme contribue à maintenir une humidité plus constante, favorable au développement des plantes, tout en réduisant la fréquence et le volume des apports en eau.
Une application concrète dans la serre géodésique
Intégrées directement au sol de la serre, ces billes hydro-régulatrices participent à :
la réduction de la consommation d’eau,
la limitation du stress hydrique des plantes,
l’expérimentation de solutions durables en conditions réelles.
La serre géodésique devient ainsi un espace d’expérimentation pédagogique, permettant de tester des innovations répondant aux enjeux environnementaux actuels.
Créer les matériaux pour un monde responsable
Ce projet illustre la capacité des étudiants à mobiliser les connaissances en chimie des matériaux pour répondre à des problématiques concrètes liées à la transition écologique. Il s’inscrit pleinement dans la démarche de la serre géodésique de Saint-Cyr-l’École, dont l’objectif est de faire de ce lieu un laboratoire pédagogique vivant, au service du territoire et de l’innovation durable.
Remerciements
Merci à Ethan PREMTHAI, Félicien DELMAS, Coralie LAURENT et Jules ABERLENC pour leur implication ainsi qu'à leur tuteur de projet : Nicolas Sanson.